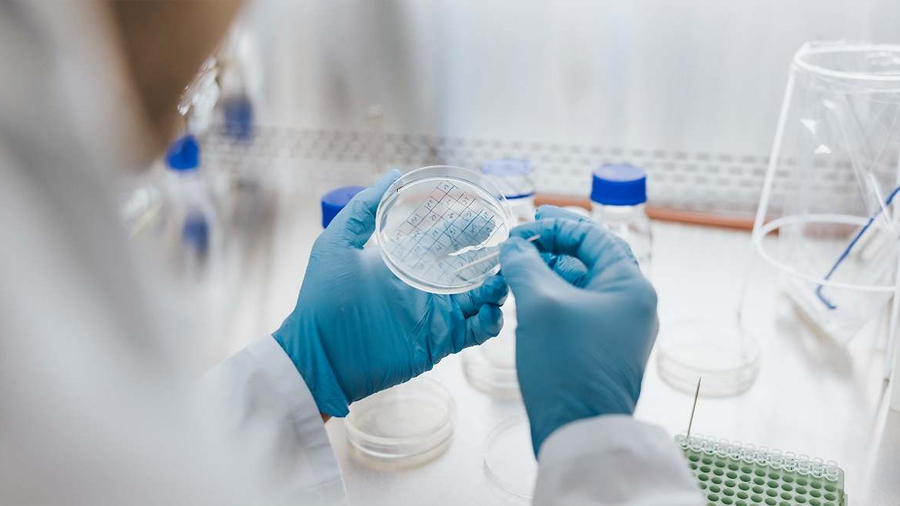

Ciencia
-

Crean un método para calcular la edad biológica real y el riesgo de enfermedades: los 10 indicadores sanguíneos clave
Un equipo internacional de investigadores de la Universidad de Konstanz desarrolló una herramienta basada en el análisis de biomarcadores Un equipo internacional coordinado por investigadores…
-

Alineación planetaria de abril 2026 en México: fecha, hora, consejos y qué planetas se verán
Mercurio, Marte, Saturno y Neptuno se reunirán, del 16 al 23 de abril de 2026, en una compacta alineación planetaria antes del amanecer. En torno…
-
Siempre estuvo ahí: investigadores españoles descubren que una molécula que produce el cuerpo humano protege frente a la gripe
La dermicidina, presente en el sudor, inactiva el virus antes de que infecte la célula, un mecanismo novedoso La dermicidina, un péptido antimicrobiano producido de…
-

Encuentran una roca de 1.200 toneladas en la selva y descubren que la culpa fue de un tsunami de 50 metros
La naturaleza no deja de sorprenderlos. En una isla del Pacífico apareció una roca enorme, lejos de la costa y en medio de la vegetación.…






